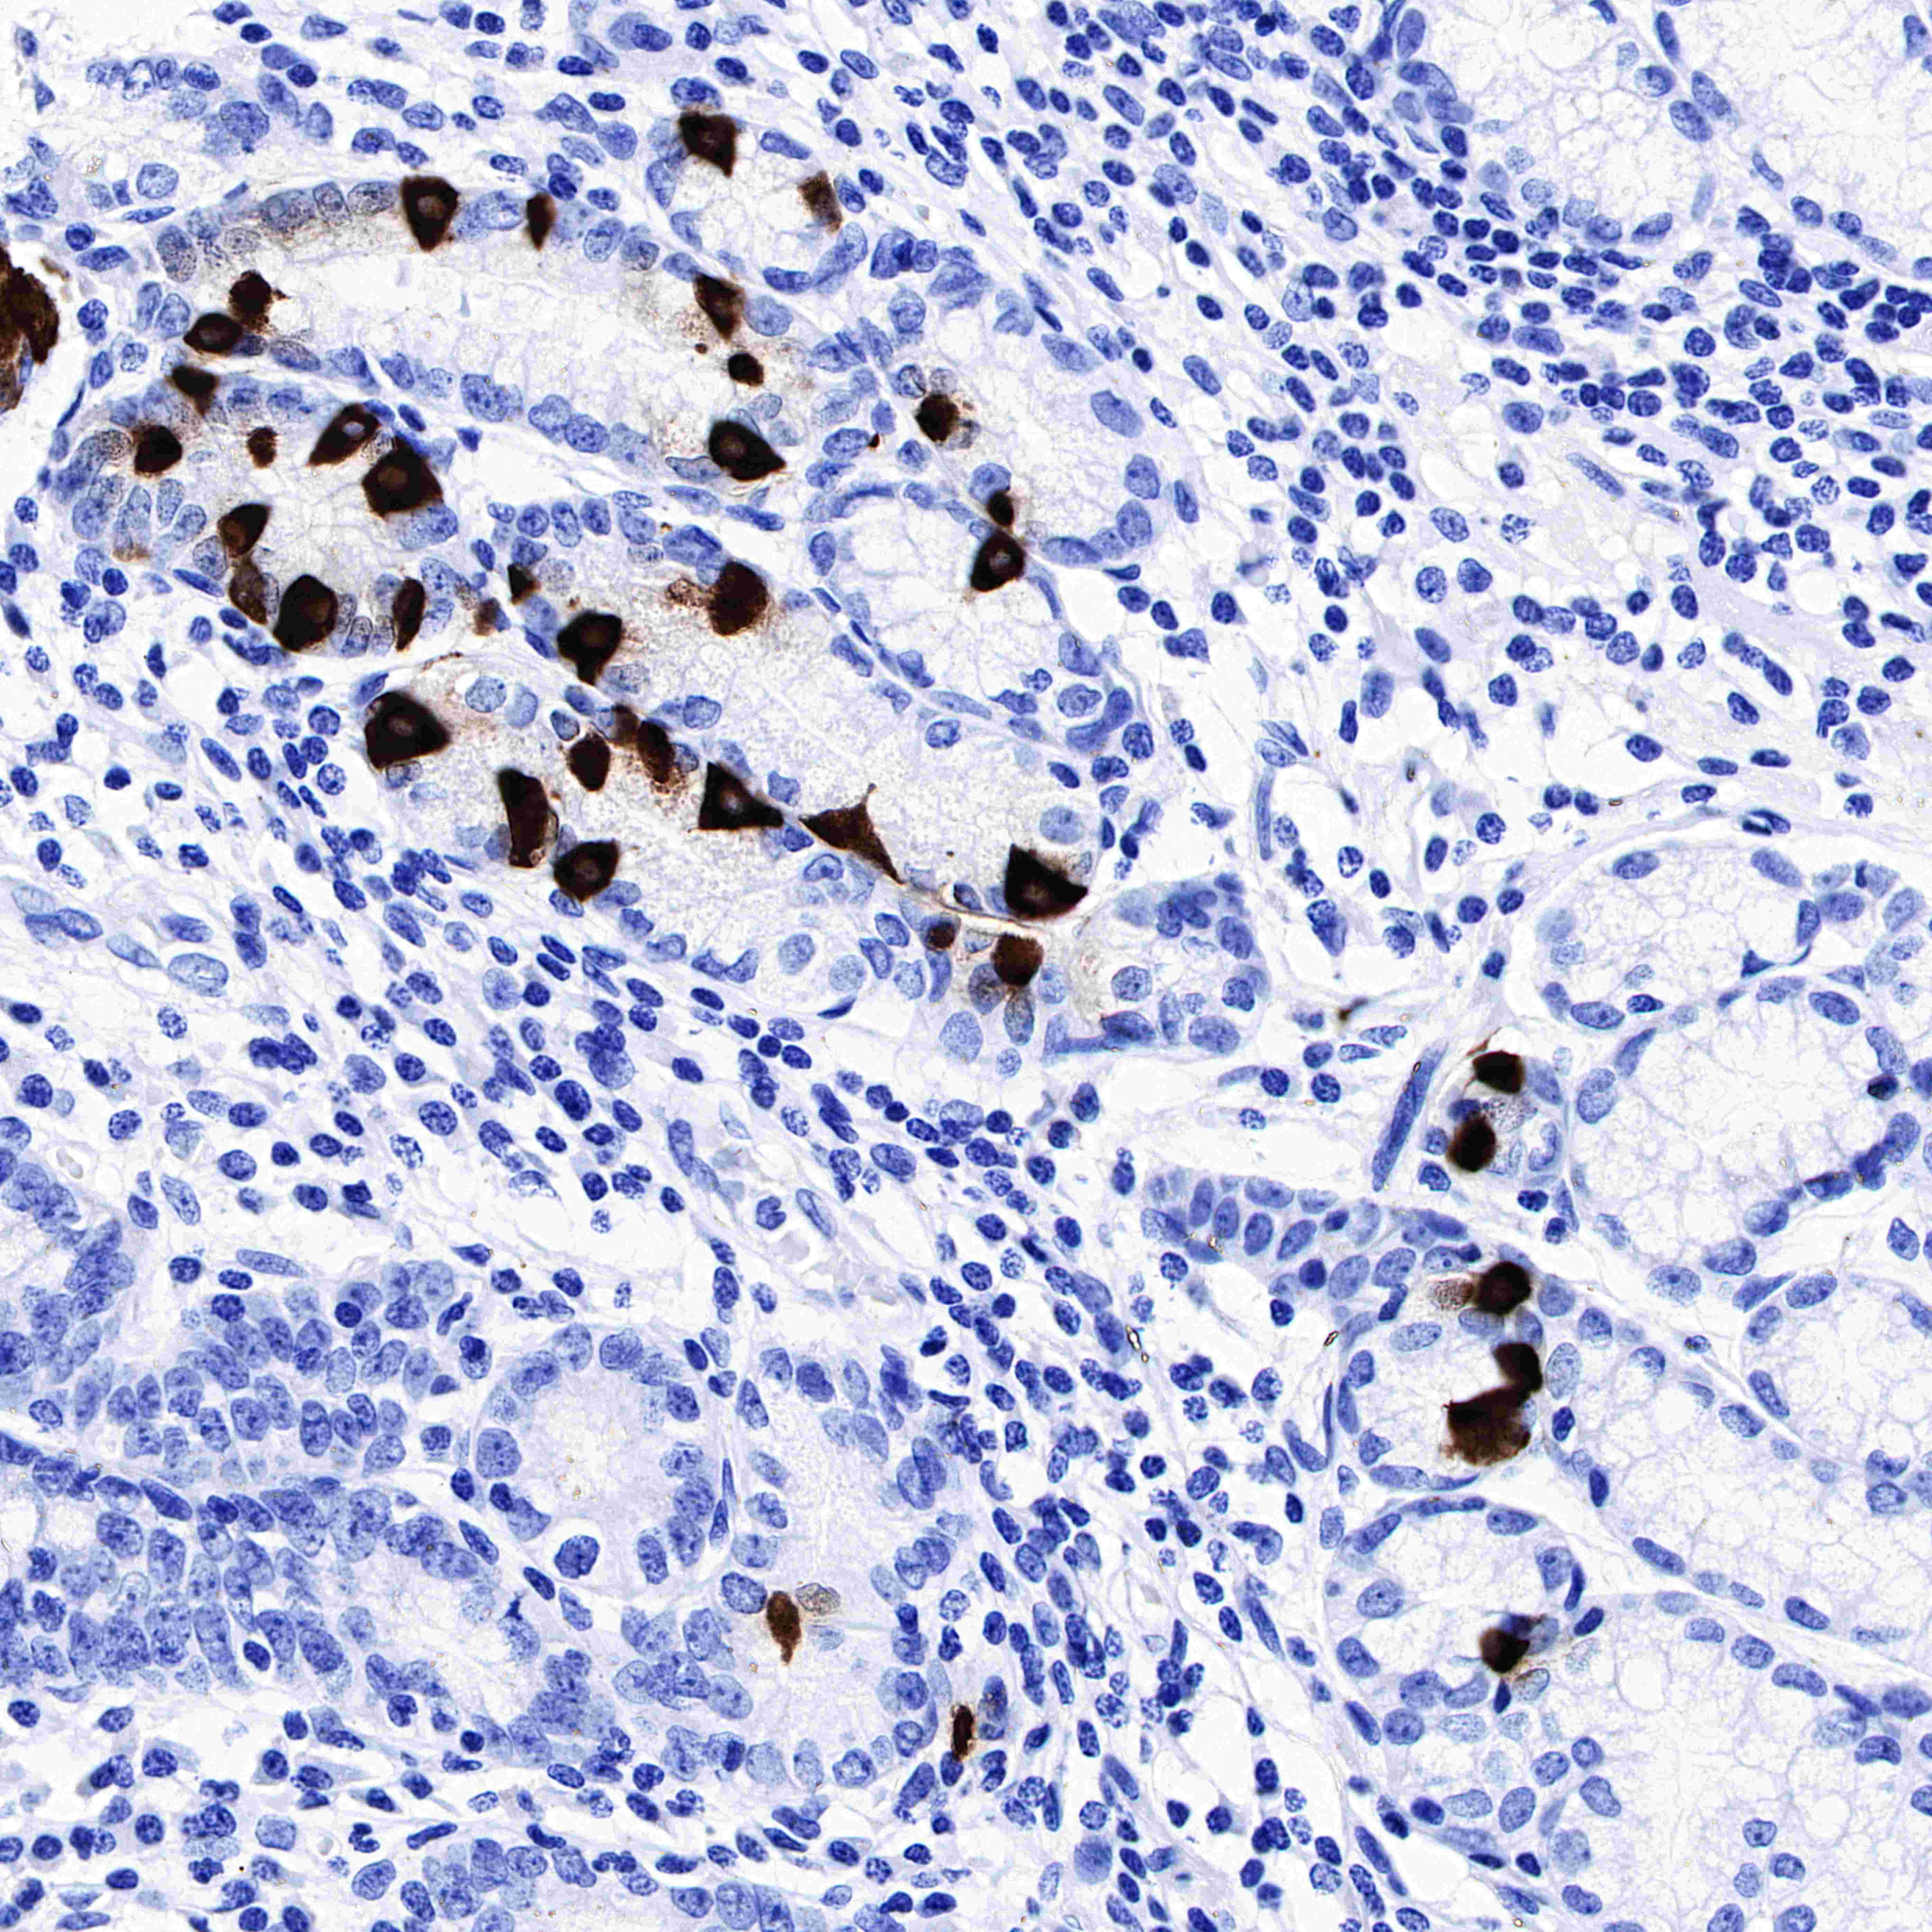

IHC shows positive staining in paraffin-embedded human gastric carcinoma. Anti-Gastrin antibody was used at 1/1000 dilution, followed by a HRP Polymer for Mouse & Rabbit IgG (ready to use). Counterstained with hematoxylin. Heat mediated antigen retrieval with Tris/EDTA buffer pH9.0 was performed before commencing with IHC staining protocol.
Product Details
Product Details
Product Specification
| Host | Rabbit |
| Antigen | Gastrin |
| Synonyms | GAS |
| Immunogen | N/A |
| Location | Secreted |
| Accession | P01350 |
| Clone Number | SDT-R068 |
| Antibody Type | Rabbit mAb |
| Application | IHC-P |
| Reactivity | Hu |
| Purification | Protein A |
| Concentration | 0.25 mg/ml |
| Physical Appearance | Liquid |
| Storage Buffer | PBS, 40% Glycerol, 0.05%BSA, 0.03% Proclin 300 |
| Stability & Storage | 12 months from date of receipt / reconstitution, -20 °C as supplied |
Dilution
| application | dilution | species |
| IHC-P | 1:1000 | null |
Background
Picture
Picture
Immunohistochemistry

IHC shows positive staining in paraffin-embedded human gastric carcinoma. Anti-Gastrin antibody was used at 1/1000 dilution, followed by a HRP Polymer for Mouse & Rabbit IgG (ready to use). Counterstained with hematoxylin. Heat mediated antigen retrieval with Tris/EDTA buffer pH9.0 was performed before commencing with IHC staining protocol.

IHC shows positive staining in paraffin-embedded human stomach (Paracancerous tissue). Anti-Gastrin antibody was used at 1/1000 dilution, followed by a HRP Polymer for Mouse & Rabbit IgG (ready to use). Counterstained with hematoxylin. Heat mediated antigen retrieval with Tris/EDTA buffer pH9.0 was performed before commencing with IHC staining protocol.

Negative control: IHC shows negative staining in paraffin-embedded human colon. Anti-Gastrin antibody was used at 1/1000 dilution, followed by a HRP Polymer for Mouse & Rabbit IgG (ready to use). Counterstained with hematoxylin. Heat mediated antigen retrieval with Tris/EDTA buffer pH9.0 was performed before commencing with IHC staining protocol.

Negative control: IHC shows negative staining in paraffin-embedded human lung adenocarcinoma. Anti-Gastrin antibody was used at 1/1000 dilution, followed by a HRP Polymer for Mouse & Rabbit IgG (ready to use). Counterstained with hematoxylin. Heat mediated antigen retrieval with Tris/EDTA buffer pH9.0 was performed before commencing with IHC staining protocol.